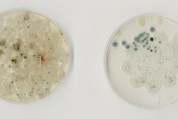
Natalie Nadeau - Student Project, Bioart: Contemporary Art and the Life Sciences, Class 2012 - School of Visual Arts, The University of Windsor
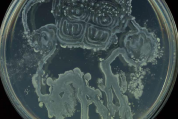
Tokio Webster - Student Project, Bioart: Contemporary Art and the Life Sciences, Class 2012 - School of Visual Arts, The University of Windsor

BioArt: Contemporary Art and the Life Sciences
THE UNIVERSITY OF WINDSOR WINTER 2012 01-27-386 BIOART: Contemporary Art and The Life Sciences Tuesdays and Thursdays 11:30-2:20 Office Hours: Tuesdays 2:30-3:30 Dr. Jennifer WilletBioArt: Contemporary Art and the Life Sciences, Class 2011, Dr. Jennifer Willet - School of Visual Arts, The University of Windsor
Class Website:
http://bioartwindsor.blogspot.com/
www.incubatorartlab.com www.jenniferwillet.com [email protected]Do artists cross the line when they breed plants or animals, or use the tools of biotechnology? Scientists routinely cross the line. So do farmers, business people, military men, and doctors. Only artists and certain religious people hesitate. Of course one of the great human dilemmas is that we do not know the extent of our powers. We invent outrageously and casually as we breath, but we have no idea where our inventions will take us. Extinction? Slavery? 1000 years in Disneyland? Even if the Holocaust had never happened, we would have good reason to worry about where knowledge of genetics and DNA will take us. We will need all the awareness we can muster to engage evolution. To the extent that art favors awareness, the more artists who cross the line the better.
George Gessert
Course Objectives:
BioArt: Contemporary Art and the Life Sciences is an innovative course that will allow for non-specialist students to engage theoretically and practically in the biological sciences towards fostering a critical participatory engagement with the biological sciences from a fine art perspective. This course is a visual art and science crossover lab intended for students from various disciplines to foster interdisciplinary exploration of the intersections between art and life through hands-on laboratory protocols, critical readings, and the production of contemporary artwork.
Together we will explore the ethical debates, issues of access and accountability, and overspecialization that arise from contemporary biotechnologies and bioart practices. Lectures will address a range of topics including; the biological sciences, historical crossovers between the fine arts and the hard sciences, and contemporary artists in the art/science field. Practical workshops will provide students with introductory experience with mammalian tissue culture, microscopy, DNA extraction and imaging, and genetic modification (amongst others) with an emphasis on health and safety and proper laboratory technique.
No previous experience in the Biological Sciences is necessary for successful completion of the class.
Students will be expected to complete readings, participate in class discussions and lab workshops, and produce individual and collaborative artworks and critical written texts.
Course Outcomes:
Students will have learned a variety of BSL1 biotechnological protocols. They will be able to successfully execute biological art projects within the lab, as well as their home. They will have exposure to scientific research conducted on the UofW campus, and a wider understanding of contemporary debates surrounding evolving biotechnologies. Additionally, students will gain further experience with group work, public speaking skills, health and safety, and critical writing skills.
There is a Lab fee of 100.00 CDN for this course. This fee will pay for all biological materials used in the class, as well as specialized biological and scientific consumables students will need to complete their individual projects. In addition, some students may choose to purchase more traditional art supplies for their individual projects – these expenses will fall to the individual student.
Evaluation:
10% Microbial Artwork:
Each student will prepare an artwork that involves the growth of microbes as an aspect of the project. This project should be documented with one of the digital microscopes, a digital camera, or digital scanners available in the SVA.
10% Very Small Art Project:
Each student will prepare a very small art project that is only viewable with the assistance of a microscope. This project should include some biological component – and should be documented with one of the digital microscopes in the lab.
20% Individual Research Paper:
Each student will develop an individual research paper exploring questions of bioart from critical, historical, ethical, and aesthetic perspectives. Theoretical sources can be drawn from class readings and the class bibliography – however, students are also encouraged to draw upon communication theory, media criticism, literary criticism, notions of post modernity and the post-human, gender theory and post-colonial theory from outside sources. Papers should be approximately 6 pages long, plus a one-page bibliography.
40% Individual or Collaborative Bioart Project:
Each student will devise an individual or collaborative bioart project. This work can be completed either in the laboratory (with permissions) or at home. Students are encouraged to work in consultation with the instructor in developing their project. Amateur science texts will be made available to the class, to assist in developing individual artworks and protocols.
20% Class Participation:
Students will be expected to attend ALL classes, and actively participate in class discussions, analyzing readings, participating in field trips, and workshops. Additionally, each student will be expected to make a minimum of two posts to the class blog. This can be in the form of critical discussion, images, announcements, poetry, web links, etc.
Proposed Field Trips: (currently under negotiation)
Day Hike Field Trip University of Windsor: Biological Sciences University of Windsor: Anatomy Lab
SYLLABUS: Subject to change.
Jan. 05 · Introduction to course and outline.
· Introduction to Bioart facilities, Health and Safety.
Jan. 10 · Introduction to Bioart Lecture.
Jan. 12 · Reading Class discussion: “Labs Shut Open: A Biotech Hands-on Workshop for artists.”
· Sterile Technique / Bacteria / Yeast lab
Jan. 17 · Agar Plate Preparation (small and large – foreign objects? – alternative containers?)
Jan. 19 · Class time for microbial artwork.
Jan. 24 · DUE DATE: Microbial Artwork + Documentation
Jan. 26 · GFP Modification of Bacteria
Jan.31 · Reading Class discussion: “Biology as Ideology”
· follow up GFP Modification of Bacteria
Feb. 02 · Introduction to Microscopy - very small art!
Feb. 07 · Class time for very small art
Feb. 09 · Artist Presentation / or / science lab visit?
Feb. 14 · Artist Presentation / or / science lab visit?
Feb. 16 · DUE DATE: Very Small Art Projects + Documentation
· Class Critique: Very Small Art Projects
Feb. 21-23 · Study Week – No Classes
Feb. 28 · Make Cheese!
Mar. 01 · TBA
Mar. 06 · DIY DNA Extraction
Mar.08 · BioART Paper Due
· Willet Artist Presentation / Laboratory Aesthetics Drawings
Mar. 13 · Individual Meetings (Materials Requests)
Mar. 14 · Last Day to Withdraw from Classes.
Mar. 15 · Tissue Culture (reading)
Mar. 20 · Tissue Culture
Mar. 22 · Tissue Culture (Materials Requests)
Mar. 27 · Individual Meetings
Mar. 29 · Cell Break: Day Hike in a natural location off campus!
Apr. 03 · Open Work session
Apr. 05 · DUE DATE: Final Projects Due
· Class Critique: Final Projects Due